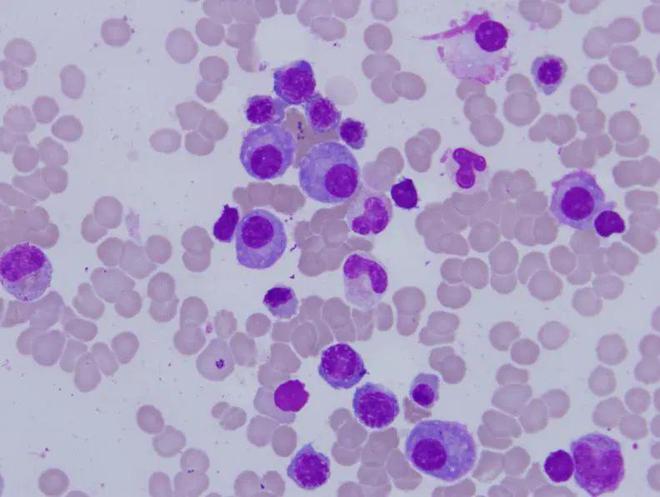
什么食物能补锌（食物补锌有哪些食物是最好）-硒宝网

什么食物能补锌(食物补锌有哪些食物是最好)
?吃什么补锌?三款食物让你永不缺锌
锌是人类正常发育时必须的营养成分,特别是处于发育期的儿童和青少年,如果身体缺锌就会发育不良,有时会出现厌食和偏食等不良症状。这时可以多吃一些含锌高的食材。现在的孩子都比较挑食,所以总会有缺锌的孩子。那么生活中哪些食物含锌高而且易于人体吸收和利用呢?哪几类孩子属于容易缺锌的高危人群?下面大家就跟随小编一起来了解一下吧。
目录
1锌的生理功用
(1)参加人体内许多金属酶的组成锌是人机体中200多种酶的组成部分,在按功能划分的六大酶类(氧化还原酶类、转移酶类、水解酶类、裂解酶类、异构酶类和合成酶类)中,每一类中均有含锌酶。人体内重要的含锌酶有碳酸酐酶、胰羧肽酶、DNA聚合酶、醛脱氢酶、谷氨酸脱氢酶、苹果酸脱氢酶、乳酸脱氢酶、碱性磷酸酶、丙酮酸氧化酶等。它们在组织呼吸以及蛋白质、脂肪、糖和核酸等的代谢中有重要作用。催化CO2+H2O→H2CO3反应的碳酸酐酶以足够的速率消除CO2而维持生命。因此,这种酶可使人免于CO2中毒,没有这种酶就不能以足够的速率消除CO2而维持生命。因此,这种酶对于CO2输送的重要性有如红细胞对氧的输送。在人体红细胞中,每mol的碳酸酐酶都含有1g原子的锌。已证明在正常的病理条件下,红细胞中锌的含量与碳酸酐酶活力之间存在相关。
来自胰液的羧肽酶A和B,每mol蛋白质都含有1g原子的锌,锌原子对这些酶的催化作用是必需的。在试管内羧肽酶的锌可被其它金属如钴、锰、镍、铁、镉、汞和铅所取代,结果显著改变了催化作用和基质的特异性。羧肽酶A和B两者均随胰液进入肠道,参加蛋白质水解。
其它含锌酶,如碱性磷酸酶,乳酸脱氢酶、丙酮酸羧化酶、苹果酸脱氢酶在蛋白质、脂肪、糖的代谢中都有重要的作用。
(2)促进机体的生长发育和组织再生锌是调节基因表达即调节DNA复制、转译和转录的DNA聚合酶的必需组成部分,因此,缺锌动物的突出的症状是生长、蛋白质合成、DNA和RNA代谢等发生障碍。在人体,缺锌儿童的生长发生到严重影响而出现缺锌性侏儒症。不论成人或儿童缺锌都能使创伤的组织愈合困难。锌不仅对于蛋白质和核酸的合成而且对于细胞的生长、分裂和分化的各个过程都是必需的。因此,锌对于正处于生长发育旺盛期的婴儿、儿童和青少年,对于组织创伤的患者,是更加重要的营养素。锌对于胎儿的生长发育很重要。妊娠期间甚至短时期缺锌,也可使大鼠的后代发生先天性畸形。包括骨骼、大脑、心脏、眼、胃肠道和肺。胎儿的死亡率也增加。
(3)促进食欲动物和人缺锌时,出现食欲缺乏??诜榘彼嵋栽斐扇斯と毙渴?组氨酸可夺取体内结合于白蛋白的锌,使之从尿中排出,引起体内缺锌),也可引起食欲显著减退。这都证明锌维持正常食欲中的作用。
(4)锌缺乏对味觉系统有不良的影响,导致味觉迟钝。锌可能通过参加构成一种含锌蛋白-唾液蛋白对味觉及食欲起促进作用。

(5)促进性器官和性机能的正常缺锌大鼠前列腺和精囊发育不全,精子之减少,给锌后可使之恢复。已发生睾丸退变者则不能恢复。在人体,缺锌使性成熟推迟,性器官发育不全,性机能降低,精子减少,第二性征发育不全,月经不正?;蛲V?,如及时给锌治疗。这些症状都好转或消失。
(6)保护皮肤健康动物和人都可因缺锌而影响皮肤健康,出现皮肤粗糙、干燥等现象。在组织学上可见上皮角化和食道的类角化(这可能部分地与硫和粘多糖代谢异常有关,在缺锌动物身上已发现了这种代谢异常)。这时皮肤创伤治愈变慢,对感染的易感性增加。
(7)参加免疫功能过程锌在保持免疫反应中的作用近些年来已引起注意。根据它在DNA合成中的作用,推测它在参加包括免疫反应细胞在内的细胞复制中起着重要作用。缺锌动物的胸腺萎缩,胸腺和脾脏重量减轻。人和动物缺锌时T细胞功能受损,引起细胞介导免疫改变,使免疫力降低。同时缺锌还可能使有免疫力的细胞增殖减少,胸腺因子活性降低,DNA合成减少,细胞表面受体发生变化。因此,机体缺锌可削弱免疫机制,降低抵抗力,使机体易受细菌感染。1978年在牙买加的一次研究提示,锌缺乏是蛋白质-能量营养不良婴儿免疫力缺乏的原因。
2?吃什么补锌?三款食物让你永不缺锌
油泼莴笋
原料:嫩莴笋、葱丝、橄榄油(或花生油)、盐、味精水、花椒。
制作方法
1、将莴笋去皮洗净,切成6厘米长条状。
2、己烧锅加水,待水开后,放入莴笋,大火滚开后关火。随即放入盛有冷水的容器中,过水后捞出放入盘中,撒少许盐、味精、水腌制,并摆放好葱丝待用。
3、热锅下油至80度左右,放入适量花椒粒,煸至花椒变黑关火,捞出花椒粒,将油淋入摆放好的莴笋上即可。 此道菜清淡、爽口,含锌约7、86毫克。莴笋所含矿物质比其他蔬菜高5倍,对儿童缺锌引起的消化不良、厌食等症有很好的疗效。

萝卜番茄汤
原料:胡萝卜、西红柿、鸡蛋、姜丝、葱末、花生油、盐、味精、白糖。
制作方法
1、胡萝卜、西红柿去皮切厚片。
2、热锅下油,倒入姜丝煸炒几下后放入胡萝卜翻炒几次,注入清汤,中火烧开,待胡萝卜熟时,下入西红柿,调入盐、味精、白糖,把鸡蛋打散倒入,撒上葱花即可。 此汤含锌量约35毫克。西红柿有清热解毒的作用,所含胡萝卜素及矿物质是缺锌补益的佳品。
1.银丝羹
原料:蛋黄豆腐(又名日本豆腐)、干贝、木耳、香菜、上汤、葱姜等调料。
制作
1.把蛋黄豆腐及洗净去蒂的黑木耳切丝,用冷水泡着,葱姜切丝备用。
2.干贝蒸软,凉后搓碎,上汤烧开后下入各种配料。
3.烧开调味、勾芡,最后撒入香菜末。
营养小秘诀:蛋黄、干贝和木耳是食物中补锌的高手,清淡鲜香的口味。
2.桂圆猪心
原料:桂圆肉、猪心、姜、胡椒、 绍酒、盐等。
制作
1.将猪心剖开,去掉脂肪、筋膜,再将桂圆肉洗净,姜切片。
2.将猪心汆水、过凉,然后加入桂圆肉、姜片及适量水。
3.转小火煮,调好味。
营养小秘诀:桂圆猪心不仅能补充丰富的锌,还具有养血补气、健脾开胃的功效。
结语:通过上面的介绍,想必大家都了解到了补锌吃什么食物好了吧。在日常生活中,我们经常的能够发现很多的食物的营养含量都有锌,所以我们饮食补锌是最好的方法了。但是要注意到营养均衡哦。
3补锌的作用
锌是人体不可缺少的微量元素,如孩子缺锌则影响生长发育,智力低下。若孩子体内不缺锌而滥补,就会雪上加霜。道理何在呢?原来人体内的微量元素都有一定的含量和比例,既不可少,也不可多。
婴幼儿生长发育较快,对锌的需要量相对大一些,但并非多多益善,要是把含锌的药物当成营养药,天天让孩子服用,就会危害健康。若补锌过多,可使体内的维生素C和铁的含量减少,抑制铁的吸收和利用,从而引起缺铁性贫血。当孩子体内锌元素过多, 钙元素减少时,在镁离子的作用下,可抑制吞噬细胞的活性,免疫力下降,抗病能力差。经常给孩子服含锌的药物,还会使体内锌、铜元素的比值增大,影响胆固醇的代谢,使血脂升高,促使动脉发生粥样硬化,为日后得心脑血管病埋下隐患。
此外,体内锌含量过高,有诱发癌症的危险??杉?,对锌要有一个正确的认识,要想使孩子体内不缺锌,家长应学会科学的育儿方法。首先是做到母乳喂养,因母乳中有足够婴儿生长发育所需的锌元素,4个月起要逐渐为孩子添加辅食,特别是瘦肉、鸡蛋、动物肝、牡蛎、花生米、核桃仁等食品中锌含量较高,可视具体情况让孩子食用要从小教育孩子养成不挑食、不偏食的好习惯,注重饮食结构合理平衡,粗细杂粮混合吃,这样孩子一般是不会缺锌的。
4儿童缺锌的临床表现
1、短期内反复患感冒、支气管炎或肺炎等。
2、经常性食欲不振,挑食、厌食、过分素食、异食(吃墙皮、土块、煤渣等),小婴儿常表现喂养困难、明显消瘦。
3、生长发育迟缓,体格矮小(不长个),第二性征发育不全或不发育。
4、易激动、脾气大、多动、注意力不能集中、记忆力差、学习往往落后,甚至影响智力发育。
5、视力低下、视力减退,甚至夜盲症,暗适应力差。

6、头发枯黄易脱落,佝偻病时补钙、补维生素D效果不好。
7、经常性皮炎、痤疮,采取一般性治疗效果不佳。
5几类孩子属于容易缺锌的高危人群
1、母亲在怀孕期间摄入锌不足的孩子:孕妇的血锌水平维持在89.4毫克/分升左右。如果孕妇的一日三餐中缺乏含锌的食品,势必会影响胎儿对锌的利用,使体内贮备的锌过早被应用,这样的孩子出生后就容易出现缺锌症状。
2、早产儿:如果孩子不能在母体内孕育足够的时间而提前出生,就容易失去在母体内贮备锌元素的黄金时间(一般是在孕末期的最后1个月),造成先天不足。
3、非母乳喂养的孩子:母乳中含锌量大大超过普通牛奶,更重要的是其吸收率高达42%,这是任何非母乳食品都不能比的。
4、过分偏食的孩子:有些“素食者”,从小拒绝吃任何肉类、蛋类、奶类及其制品,这样非常容易缺锌,因此,应从小就培养良好的饮食习惯,不偏食,不挑食。
5、过分好动的孩子:不少孩子尤其是男孩子,过分好动,经常出汗甚至大汗淋漓,而汗水也是人体排锌的渠道之一。据测定,一天中大汗淋漓可丢失锌1.3毫克。
6、罹患佝偻病的孩子:这些孩子因治疗疾病需要而服用钙制剂,而体内钙水平升高后就会抑制肠道对锌的吸收。同时,因为这样的患儿食欲也相对较差,食物中的锌摄入减少,很容易发生缺锌。
7、一些特殊情况下的孩子:土壤含锌过低,使当地农产品缺锌;孩子的消化吸收功能不良,一些疾病、药物如四环素等与锌结成难溶的复合物妨碍吸收。
